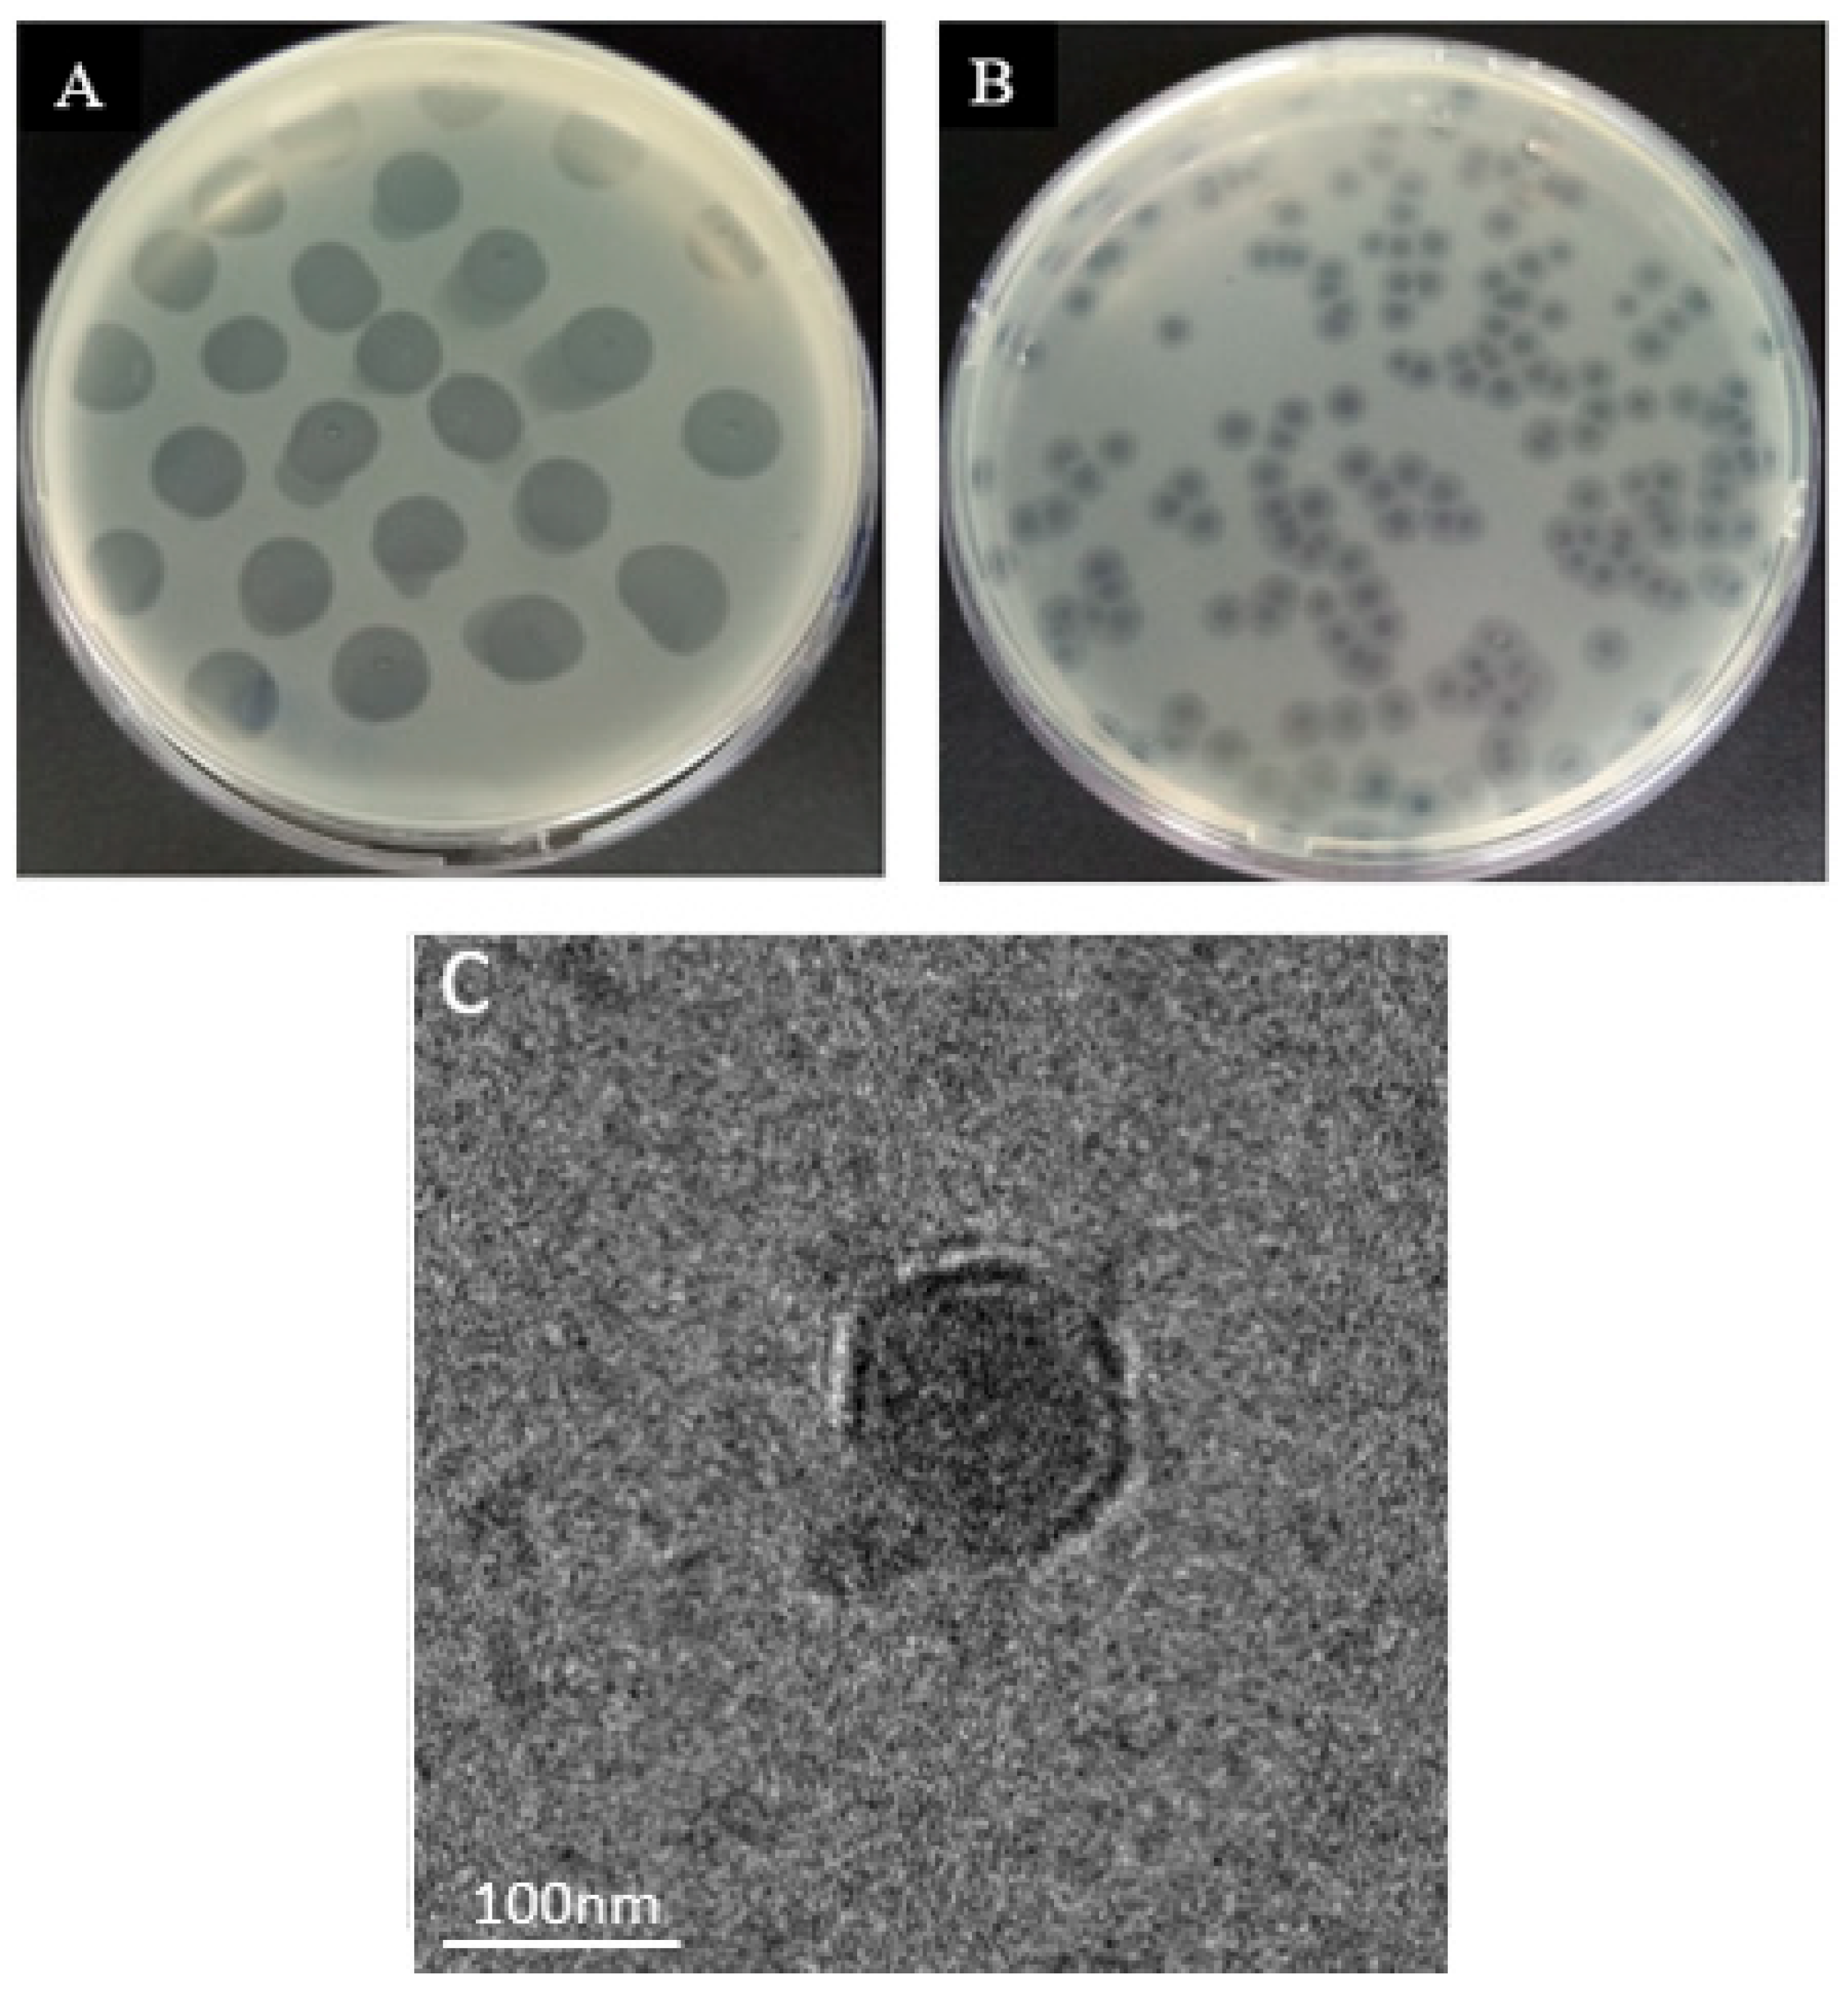
Antibiotics 12 00497 g002 Antibiotics 12 00497 g002

RETRACTED: Isolation and Characterization of a Novel Lytic Phage, vB_PseuP-SA22, and Its Efficacy against Carbapenem-Resistant Pseudomonas aeruginosa
Abstract
1. Introduction
2. Materials and Methods
2.1. Bacterial Strains and Culture Condition
2.2. Antibiotic Sensitivity Test
2.3. Enrichment and Isolation of Bacteriophages
2.4. Spot Assay
2.5. Purification
2.6. Concentration of Phages
2.7. Bacteriophage Titer Determination
2.8. Stability of P. aeruginosa Phage
2.8.1. Thermal Stability
2.8.2. Phage pH Stability Test
2.9. Bacterial Reduction Assay
2.10. Determination of Optimal Multiplicity of Infection (MOI)
2.11. Phage Adsorption Assay
2.12. One-Step Growth Curve
2.13. Host Spectrum
2.14. Transmission Electron Microscopy (TEM)
2.15. Biofilm Formation and Reduction Assay
2.15.1. Test Tube Biofilm Production Assay
2.15.2. Microtiter Plate Biofilm Production and Reduction Assay
2.16. Scanning Electron Microscopy
2.17. Extraction of Bacteriophage DNA
2.18. Whole-Genome Sequence and Bioinformatic Analysis
2.19. Phylogenetic Analysis
2.20. Comparative Genomic Analysis
2.21. Statistical Analysis
2.22. Nucleotide Sequence Accession Number
3. Results
3.1. Identification of the Host Bacteria and Its Antibiotic Sensitivity Profile
3.2. Phage Isolation and Morphology
3.3. Phage Adsorption Assay and One-Step Growth Curve
3.4. Stability Test and Bacterial Challenge Test
3.5. Host Range
3.6. Genomic Analysis of the vB_PseuP-SA22 Phage Genome
3.7. Predicted tRNA and Rho-Independent Transcription Terminators
3.8. Phylogenetic Analysis
3.9. Comparative Genomic Analysis
3.10. Biofilm Production
3.11. Biofilm Reduction Assay
4. Discussion
5. Conclusions
Supplementary Materials
Author Contributions
Funding
Institutional Review Board Statement
Informed Consent Statement
Data Availability Statement
Conflicts of Interest
References
- Lyczak:, J.B.; Cannon, C.L.; Pier, G.B. Establishment of Pseudomonas aeruginosa infection: Lessons from a versatile opportunist. Microb. Infect. 2000, 2, 1051–1060. [Google Scholar] [CrossRef] [PubMed]
- Bassetti, M.; Merelli, M.; Temperoni, C.; Astilean, A. New antibiotics for bad bugs: Where are we? Ann. Clin. Microbiol. Antimicrob. 2013, 12, 22. [Google Scholar] [CrossRef] [PubMed]
- Tolker-Nielsen, T. Pseudomonas aeruginosa biofilm infections: From molecular biofilm biology to new treatment possibilities. Apmis 2014, 122, 1–51. [Google Scholar] [CrossRef] [PubMed]
- Nathan, C. Resisting antimicrobial resistance. Nat. Rev. Microbiol. 2020, 18, 259–260. [Google Scholar] [CrossRef] [PubMed]
- Reygaert, W.C. An overview of the antimicrobial resistance mechanisms of bacteria. AIMS Microbiol. 2018, 4, 482. [Google Scholar] [CrossRef]
- Alharbi, M.G.; Al-Hindi, R.R.; Esmael, A.; Alotibi, I.A.; Azhari, S.A.; Alseghayer, M.S.; Teklemariam, A.D. The “Big Six”: Hidden Emerging Foodborne Bacterial Pathogens. Trop. Med. Infect. Dis. 2022, 7, 356. [Google Scholar] [CrossRef]
- Meletis, G. Carbapenem resistance: Overview of the problem and future perspectives. Ther. Adv. Infect. Dis. 2016, 3, 15–21. [Google Scholar] [CrossRef]
- Arya, S.S.; Sharma, M.M.; Rookes, J.E.; Cahill, D.M.; Lenka, S.K. Vanilla modulates the activity of antibiotics and inhibits efflux pumps in drug-resistant Pseudomonas aeruginosa. Biologia 2021, 76, 781–791. [Google Scholar] [CrossRef]
- WHO. WHO Publishes List of Bacteria for Which New Antibiotics are Urgently Needed; WHO: Geneva, Switzerland, 2017. [Google Scholar]
- Zeineldin, M.; Esmael, A.; Al-Hindi, R.R.; Alharbi, M.G.; Ashenafi Bekele, D.; Teklemariam, A.D. Beyond the Risk of Biofilms: An Up-and-Coming Battleground of Bacterial Life and Potential Antibiofilm Agents. Life 2023, 13, 503. [Google Scholar] [CrossRef]
- Coronel-Olivares, C.; Reyes-Gómez, L.M.; Hernández-Muñoz, A.; Martínez-Falcón, A.P.; Vázquez-Rodríguez, G.A.; Iturbe, U. Chlorine Disinfection of Pseudomonas aeruginosa, Total Coliforms, Escherichia coli and Enterococcus faecalis: Revisiting Reclaimed Water Regulations. Water Sci. Technol. 2011, 64, 2151–2157. [Google Scholar] [CrossRef]
- Watters, C.; DeLeon, K.; Trivedi, U.; Griswold, J.A.; Lyte, M.; Hampel, K.J.; Wargo, M.J.; Rumbaugh, K.P. Pseudomonas aeruginosa biofilms perturb wound resolution and antibiotic tolerance in diabetic mice. Med. Microbiol. Immunol. 2013, 202, 131–141. [Google Scholar] [CrossRef] [PubMed]
- Høiby, N.; Ciofu, O.; Bjarnsholt, T. Pseudomonas aeruginosa biofilms in cystic fibrosis. Future Microbiol. 2010, 5, 1663–1674. [Google Scholar] [CrossRef] [PubMed]
- Thi, M.T.T.; Wibowo, D.; Rehm, B.H. Pseudomonas aeruginosa biofilms. Int. J. Mol. Sci. 2020, 21, 8671. [Google Scholar] [CrossRef] [PubMed]
- Knecht, L.E.; Veljkovic, M.; Fieseler, L. Diversity and function of phage encoded depolymerases. Front. Microbiol. 2020, 10, 2949. [Google Scholar] [CrossRef]
- Esmael, A.; Abo-Elmaaty, S.A.; Khafaga, E.M.; Abdelrahman, S.; Hassan, M.G. Efficacy of three lytic bacteriophages for eradicating biofilms of multidrug-resistant Proteus mirabilis. Arch. Virol. 2021, 166, 3311–3322. [Google Scholar] [CrossRef]
- Jensen, P.Ø.; Givskov, M.; Bjarnsholt, T.; Moser, C. The immune system vs. Pseudomonas aeruginosa biofilms. FEMS Immunol. Med. Microbiol. 2010, 59, 292–305. [Google Scholar] [CrossRef]
- Sharma, D.; Misba, L.; Khan, A.U. Antibiotics versus biofilm: An emerging battleground in microbial communities. Antimicrob. Resist. Infect. Control. 2019, 8, 76. [Google Scholar] [CrossRef]
- Esmael, A.; Hassan, M.G.; Amer, M.M.; Abdelrahman, S.; Hamed, A.M.; Abd-raboh, H.A.; Foda, M.F. Antimicrobial activity of certain natural-based plant oils against the antibiotic-resistant acne bacteria. Saudi J. Biol. Sci. 2020, 27, 448–455. [Google Scholar] [CrossRef]
- Tian, F.; Li, J.; Nazir, A.; Tong, Y. Bacteriophage—A promising alternative measure for bacterial biofilm control. Infect. Drug Resist. 2021, 14, 205. [Google Scholar] [CrossRef]
- Esmael, A.; Azab, E.; Gobouri, A.A.; Nasr-eldin, M.A.; Moustafa, M.M.A.; Mohamed, S.A.; Badr, O.A.M.; Abdelatty, A.M. Isolation and characterization of two lytic bacteriophages infecting a multi-drug resistant Salmonella typhimurium and their efficacy to combat salmonellosis in ready-to-use foods. Microorganisms 2021, 9, 423. [Google Scholar] [CrossRef]
- Blundell-Hunter, G.; Enright, M.C.; Negus, D.; Dorman, M.J.; Beecham, G.E.; Pickard, D.J.; Wintachai, P.; Voravuthikunchai, S.P.; Thomson, N.R.; Taylor, P.W. Characterisation of bacteriophage-encoded depolymerases selective for key Klebsiella Pneumoniae capsular exopolysaccharides. Front. Cell. Infect. Microbiol. 2021, 11, 686090. [Google Scholar] [CrossRef] [PubMed]
- Matsuzaki, S.; Rashel, M.; Uchiyama, J.; Sakurai, S.; Ujihara, T.; Kuroda, M.; Ikeuchi, M.; Tani, T.; Fujieda, M.; Wakiguchi, H. Bacteriophage therapy: A revitalized therapy against bacterial infectious diseases. J. Infect. Chemother. 2005, 11, 211–219. [Google Scholar] [CrossRef] [PubMed]
- Soothill, J. Use of bacteriophages in the treatment of Pseudomonas aeruginosa infections. Expert Rev. Anti-Infect. Ther. 2013, 11, 909–915. [Google Scholar] [CrossRef] [PubMed]
- Abo-Elmaaty, S.A.; Esmael, A.; Bdelrahman, S.; Tarek, E.; Hassan, M.G. Studies on the Application of Bacteriophages and Silver Nanparticles in The Treatment of Pseudomonas spp. Egypt. Acad. J. Biol. Sci. G. Microbiol. 2022, 14, 23–39. [Google Scholar] [CrossRef]
- Sulakvelidze, A.; Alavidze, Z.; Morris, J.G. Bacteriophage Therapy. Antimicrob. Agents Chemother. 2001, 45, 649–659. [Google Scholar] [CrossRef] [PubMed]
- Verbeken, G.; De Vos, D.; Vaneechoutte, M.; Merabishvili, M.; Zizi, M.; Pirnay, J.-P. European regulatory conundrum of phage therapy. Future Microbiol. 2007, 2, 485–491. [Google Scholar] [CrossRef] [PubMed]
- Waters, V.; Grimwood, K. Defining chronic Pseudomonas aeruginosa infection in cystic fibrosis. J. Cyst. Fibros. 2018, 17, 292–293. [Google Scholar] [CrossRef]
- Holguín, A.V.; Rangel, G.; Clavijo, V.; Prada, C.; Mantilla, M.; Gomez, M.C.; Kutter, E.; Taylor, C.; Fineran, P.C.; Barrios, A.F.G. Phage ΦPan70, a putative temperate phage, controls Pseudomonas aeruginosa in planktonic, biofilm and burn mouse model assays. Viruses 2015, 7, 4602–4623. [Google Scholar] [CrossRef]
- Latz, S.; Krüttgen, A.; Häfner, H.; Buhl, E.M.; Ritter, K.; Horz, H.-P. Differential effect of newly isolated phages belonging to PB1-Like, phiKZ-Like and LUZ24-Like Viruses against Multi-Drug Resistant Pseudomonas aeruginosa under varying growth conditions. Viruses 2017, 9, 315. [Google Scholar] [CrossRef]
- Adnan, M.; Shah, M.R.A.; Jamal, M.; Jalil, F.; Andleeb, S.; Nawaz, M.A.; Pervez, S.; Hussain, T.; Shah, I.; Imran, M. Isolation and characterization of bacteriophage to control multidrug-resistant Pseudomonas aeruginosa planktonic cells and biofilm. Biologicals 2020, 63, 89–96. [Google Scholar] [CrossRef]
- Lin, D.M.; Koskella, B.; Lin, H.C. Phage Therapy: An Alternative to Antibiotics in the Age of Multi-Drug Resistance. World J. Gastrointest. Pharmacol. Ther. 2017, 8, 162–173. [Google Scholar] [CrossRef] [PubMed]
- Humphries, R.; Bobenchik, A.M.; Hindler, J.A.; Schuetz, A.N. Overview of changes to the clinical and laboratory standards institute performance standards for antimicrobial susceptibility testing, M100. J. Clin. Microbiol. 2021, 59, e00213-21. [Google Scholar] [CrossRef] [PubMed]
- Van Twest, R.; Kropinski, A.M. Bacteriophage Enrichment From Water and Soil. Methods Mol. Biol. 2009, 501, 15–21. [Google Scholar] [CrossRef] [PubMed]
- Pereira, C.; Silva, Y.J.; Santos, A.L.; Cunha, A.; Gomes, N.C.; Almeida, A. Bacteriophages With Potential for Inactivation of Fish Pathogenic Bacteria: Survival, Host Specificity and Effect on Bacterial Community Structure. Mar. Drugs 2011, 9, 2236. [Google Scholar] [CrossRef]
- Gencay, Y.E.; Birk, T.; Sørensen, M.C.; Brøndsted, L. Methods for Isolation, Purification, and Propagation of Bacteriophages of Campylobacter Jejuni. Methods Mol. Biol. 2017, 1512, 19–28. [Google Scholar] [CrossRef]
- Adams, M.H. Bacteriophages; Citeseer: Princeton, NJ, USA, 1959. [Google Scholar]
- Teklemariam, A.D.; Alharbi, M.G.; Al-Hindi, R.R.; Alotibi, I.; Aljaddawi, A.A.; Azhari, S.A.; Esmael, A. Isolation and Characterization of Chi-like Salmonella Bacteriophages Infecting Two Salmonella enterica Serovars, Typhimurium and Enteritidis. Pathogens 2022, 11, 1480. [Google Scholar] [CrossRef]
- Thung, T.; Siti Norshafawatie, B.; Premarathne, J.; Chang, W.; Loo, Y.; Kuan, C.; New, C.; Ubong, A.; Ramzi, O.; Mahyudin, N. Isolation of food-borne pathogen bacteriophages from retail food and environmental sewage. Int. Food Res. J. 2017, 24, 450–454. [Google Scholar]
- Jurczak-Kurek, A.; Gąsior, T.; Nejman-Faleńczyk, B.; Bloch, S.; Dydecka, A.; Topka, G.; Necel, A.; Jakubowska-Deredas, M.; Narajczyk, M.; Richert, M.; et al. Biodiversity of Bacteriophages: Morphological and Biological Properties of a Large Group of Phages Isolated From Urban Sewage. Sci. Rep. 2016, 6, 34338. [Google Scholar] [CrossRef]
- Verma, V.; Harjai, K.; Chhibber, S. Characterization of a T7-like Lytic Bacteriophage of Klebsiella Pneumoniae B5055: A Potential Therapeutic Agent. Curr. Microbiol. 2009, 59, 274–281. [Google Scholar] [CrossRef]
- Wang, Z.; Zheng, P.; Ji, W.; Fu, Q.; Wang, H.; Yan, Y.; Sun, J. SLPW: A Virulent Bacteriophage Targeting Methicillin-Resistant Staphylococcus Aureus In Vitro and In Vivo. Front. Microbiol. 2016, 7, 934. [Google Scholar] [CrossRef]
- Liu, J.; Gao, S.; Dong, Y.; Lu, C.; Liu, Y. Isolation and characterization of bacteriophages against virulent Aeromonas hydrophila. BMC Microbiol. 2020, 20, 141. [Google Scholar] [CrossRef] [PubMed]
- Le, S.; Yao, X.; Lu, S.; Tan, Y.; Rao, X.; Li, M.; Jin, X.; Wang, J.; Zhao, Y.; Wu, N.C. Chromosomal DNA deletion confers phage resistance to Pseudomonas aeruginosa. Sci. Rep. 2014, 4, 4738. [Google Scholar] [CrossRef] [PubMed]
- Othman, A.M.; Esmael, A.; Abdelrahman, S.; Shraf, A.; Hassan, M.G. Biocontrol of Acinetobacter baumannii-S-MH Using Bacteriophages Isolated from Sewage Water. Egypt Acad. J. Biol. Sci. G. Microbiol. 2021, 13, 17–32. [Google Scholar] [CrossRef]
- Valentine, R.C.; Shapiro, B.; Stadtman, E. Regulation of glutamine synthetase. XII. Electron microscopy of the enzyme from Escherichia coli. Biochemistry 1968, 7, 2143–2152. [Google Scholar] [CrossRef] [PubMed]
- Ackermann, H.-W.; DuBow, M.; Jarvis, A.; Jones, L.; Krylov, V.; Maniloff, J.; Rocourt, J.; Safferman, R.; Schneider, J.; Seldin, L. The species concept and its application to tailed phages. Arch. Virol. 1992, 124, 69–82. [Google Scholar] [CrossRef]
- Di Domenico, E.G.; Toma, L.; Provot, C.; Ascenzioni, F.; Sperduti, I.; Prignano, G.; Gallo, M.T.; Pimpinelli, F.; Bordignon, V.; Bernardi, T. Development of an in vitro assay, based on the Biofilm Ring Test®, for rapid profiling of biofilm-growing bacteria. Front. Microbiol. 2016, 7, 1429. [Google Scholar] [CrossRef]
- Fong, S.A.; Drilling, A.; Morales, S.; Cornet, M.E.; Woodworth, B.A.; Fokkens, W.J.; Psaltis, A.J.; Vreugde, S.; Wormald, P.-J. Activity of bacteriophages in removing biofilms of Pseudomonas aeruginosa isolates from chronic rhinosinusitis patients. Front. Cell. Infect. Microbiol. 2017, 7, 418. [Google Scholar] [CrossRef]
- Arya, S.S.; Sharma, M.M.; Das, R.K.; Rookes, J.; Cahill, D.; Lenka, S.K. Vanillin mediated green synthesis and application of gold nanoparticles for reversal of antimicrobial resistance in Pseudomonas aeruginosa clinical isolates. Heliyon 2019, 5, e02021. [Google Scholar] [CrossRef]
- Relucenti, M.; Familiari, G.; Donfrancesco, O.; Taurino, M.; Li, X.; Chen, R.; Artini, M.; Papa, R.; Selan, L. Microscopy methods for biofilm imaging: Focus on SEM and VP-SEM pros and cons. Biology 2021, 10, 51. [Google Scholar] [CrossRef]
- Yazdi, M.; Bouzari, M.; Ghaemi, E.A.; Shahin, K. Isolation, characterization and genomic analysis of a novel bacteriophage VB_EcoS-Golestan infecting multidrug-resistant Escherichia coli isolated from urinary tract infection. Sci. Rep. 2020, 10, 7690. [Google Scholar] [CrossRef]
- Stothard, P.; Wishart, D.S. Circular genome visualization and exploration using CGView. Bioinformatics 2005, 21, 537–539. [Google Scholar] [CrossRef] [PubMed]
- Lavigne, R.; Sun, W.; Volckaert, G. PHIRE, a deterministic approach to reveal regulatory elements in bacteriophage genomes. Bioinformatics 2004, 20, 629–635. [Google Scholar] [CrossRef] [PubMed]
- Sullivan, M.J.; Petty, N.K.; Beatson, S.A. Easyfig: A genome comparison visualizer. Bioinformatics 2011, 27, 1009–1010. [Google Scholar] [CrossRef] [PubMed]
- Besemer, J.; Borodovsky, M. GeneMark: Web software for gene finding in prokaryotes, eukaryotes and viruses. Nucleic Acids Res. 2005, 33, W451–W454. [Google Scholar] [CrossRef]
- Zhou, Y.; Liang, Y.; Lynch, K.H.; Dennis, J.J.; Wishart, D.S. PHAST: A fast phage search tool. Nucleic Acids Res. 2011, 39, W347–W352. [Google Scholar] [CrossRef]
- Altschul, S.F.; Madden, T.L.; Schäffer, A.A.; Zhang, J.; Zhang, Z.; Miller, W.; Lipman, D.J. Gapped BLAST and PSI-BLAST: A new generation of protein database search programs. Nucleic Acids Res. 1997, 25, 3389–3402. [Google Scholar] [CrossRef]
- Chan, P.P.; Lowe, T.M. GtRNAdb: A database of transfer RNA genes detected in genomic sequence. Nucleic Acids Res. 2009, 37, D93–D97. [Google Scholar] [CrossRef]
- Schattner, P.; Brooks, A.N.; Lowe, T.M. The tRNAscan-SE, snoscan and snoGPS web servers for the detection of tRNAs and snoRNAs. Nucleic Acids Res. 2005, 33, W686–W689. [Google Scholar] [CrossRef]
- Chen, L.; Xiong, Z.; Sun, L.; Yang, J.; Jin, Q. VFDB 2012 update: Toward the genetic diversity and molecular evolution of bacterial virulence factors. Nucleic Acids Res. 2012, 40, D641–D645. [Google Scholar] [CrossRef]
- Kleinheinz, K.A.; Joensen, K.G.; Larsen, M.V. Applying the ResFinder and VirulenceFinder web-services for easy identification of acquired antibiotic resistance and E. coli virulence genes in bacteriophage and prophage nucleotide sequences. Bacteriophage 2014, 4, e27943. [Google Scholar] [CrossRef]
- Katoh, K.; Rozewicki, J.; Yamada, K.D. MAFFT online service: Multiple sequence alignment, interactive sequence choice and visualization. Brief. Bioinform. 2019, 20, 1160–1166. [Google Scholar] [CrossRef] [PubMed]
- Letunic, I.; Bork, P. Interactive tree of life (iTOL) v3: An online tool for the display and annotation of phylogenetic and other trees. Nucleic Acids Res. 2016, 44, W242–W245. [Google Scholar] [CrossRef] [PubMed]
- Darzentas, N. Circoletto: Visualizing sequence similarity with Circos. Bioinformatics 2010, 26, 2620–2621. [Google Scholar] [CrossRef] [PubMed]
- Hu, Y.-Y.; Cao, J.-M.; Yang, Q.; Chen, S.; Lv, H.-Y.; Zhou, H.-W.; Wu, Z.; Zhang, R. Risk factors for carbapenem-resistant Pseudomonas aeruginosa, Zhejiang Province, China. Emerg. Infect. Dis. 2019, 25, 1861. [Google Scholar] [CrossRef] [PubMed]
- Han, J.E.; Kim, J.H.; Hwang, S.Y.; Choresca Jr, C.H.; Shin, S.P.; Jun, J.W.; Chai, J.Y.; Park, Y.H.; Park, S.C. Isolation and characterization of a Myoviridae bacteriophage against Staphylococcus aureus isolated from dairy cows with mastitis. Res. Vet. Sci. 2013, 95, 758–763. [Google Scholar] [CrossRef]
- Kwiatek, M.; Parasion, S.; Mizak, L.; Gryko, R.; Bartoszcze, M.; Kocik, J. Characterization of a bacteriophage, isolated from a cow with mastitis, that is lytic against Staphylococcus aureus strains. Arch. Virol. 2012, 157, 225–234. [Google Scholar] [CrossRef]
- Zanetti, C.; Mingrone, R.; Kisielius, J.; Ueda-Ito, M.; Pignatari, A.C.C. Characterization of bacteriophages infecting clinical isolates of Pseudomonas aeruginosa stored in a culture collection. Braz. J. Med. Biol. Res. 2013, 46, 689–695. [Google Scholar] [CrossRef]
- Jamal, M.; Andleeb, S.; Jalil, F.; Imran, M.; Nawaz, M.A.; Hussain, T.; Ali, M.; Das, C.R. Isolation and characterization of a bacteriophage and its utilization against multi-drug resistant Pseudomonas aeruginosa-2995. Life Sci. 2017, 190, 21–28. [Google Scholar] [CrossRef]
- Piracha, Z.; Saeed, U.; Khurshid, A.; Chaudhary, W.N. Isolation and partial characterization of virulent phage specific against Pseudomonas aeruginosa. Glob. J. Med. Res. 2014, 14, 1–8. [Google Scholar]
- Klai, N.; Sellamuthu, B. Bacteriophages isolated from hospital wastewater and its role in controlling drug-resistant pathogens. In Current Developments in Biotechnology and Bioengineering; Elsevier: Amsterdam, The Netherlands, 2020; pp. 327–376. [Google Scholar]
- White, R.; Chiba, S.; Pang, T.; Dewey, J.S.; Savva, C.G.; Holzenburg, A.; Pogliano, K.; Young, R. Holin triggering in real time. Proc. Natl. Acad. Sci. USA 2011, 108, 798–803. [Google Scholar] [CrossRef]
- Wang, I.-N.; Smith, D.L.; Young, R. Holins: The protein clocks of bacteriophage infections. Annu. Rev. Microbiol. 2000, 54, 799–825. [Google Scholar] [CrossRef] [PubMed]
- Bailly-Bechet, M.; Vergassola, M.; Rocha, E. Causes for the intriguing presence of tRNAs in phages. Genome Res. 2007, 17, 1486–1495. [Google Scholar] [CrossRef] [PubMed]
- Jain, R.; Rivera, M.C.; Lake, J.A. Horizontal gene transfer among genomes: The complexity hypothesis. Proc. Natl. Acad. Sci. USA 1999, 96, 3801–3806. [Google Scholar] [CrossRef] [PubMed]
- Wilson, J.H. Function of the bacteriophage T4 transfer RNA’s. J. Mol. Biol. 1973, 74, 753–757. [Google Scholar] [CrossRef]
- Fister, S.; Robben, C.; Witte, A.K.; Schoder, D.; Wagner, M.; Rossmanith, P. Influence of environmental factors on phage–bacteria interaction and on the efficacy and infectivity of phage P100. Front. Microbiol. 2016, 7, 1152. [Google Scholar] [CrossRef]
- Hazem, A. Effects of temperatures, pH-values, ultra-violet light, ethanol and chloroform on the growth of isolated thermophilic Bacillus phages. New Microbiol. 2002, 25, 469–476. [Google Scholar]
- Smolarska, A.; Rabalski, L.; Narajczyk, M.; Czajkowski, R. Isolation and phenotypic and morphological characterization of the first Podoviridae lytic bacteriophages ϕA38 and ϕA41 infecting Pectobacterium parmentieri (former Pectobacterium wasabiae). Eur. J. Plant Pathol. 2018, 150, 413–425. [Google Scholar] [CrossRef]
- Fan, N.; Qi, R.; Yang, M. Isolation and characterization of a virulent bacteriophage infecting Acinetobacter johnsonii from activated sludge. Res. Microbiol. 2017, 168, 472–481. [Google Scholar] [CrossRef]
- Abedon, S.T.; Kuhl, S.J.; Blasdel, B.G.; Kutter, E.M. Phage treatment of human infections. Bacteriophage 2011, 1, 66–85. [Google Scholar] [CrossRef]
- Moldovan, R.; Chapman-McQuiston, E.; Wu, X. On kinetics of phage adsorption. Biophys. J. 2007, 93, 303–315. [Google Scholar] [CrossRef]
- Guo, Y.; Chen, P.; Lin, Z.; Wang, T. Characterization of two Pseudomonas aeruginosa viruses vB_PaeM_SCUT-S1 and vB_PaeM_SCUT-S2. Viruses 2019, 11, 318. [Google Scholar] [CrossRef] [PubMed]
- Vukotic, G.; Obradovic, M.; Novovic, K.; Di Luca, M.; Jovcic, B.; Fira, D.; Neve, H.; Kojic, M.; McAuliffe, O. Characterization, antibiofilm, and depolymerizing activity of two phages active on carbapenem-resistant Acinetobacter baumannii. Front. Med. 2020, 7, 426. [Google Scholar] [CrossRef] [PubMed]
- Oliveira, V.C.; Bim, F.L.; Monteiro, R.M.; Macedo, A.P.; Santos, E.S.; Silva-Lovato, C.H.; Paranhos, H.F.; Melo, L.D.; Santos, S.B.; Watanabe, E. Identification and characterization of new bacteriophages to control multidrug-resistant Pseudomonas aeruginosa biofilm on endotracheal tubes. Front. Microbiol. 2020, 11, 580779. [Google Scholar] [CrossRef] [PubMed]
- Yuan, Y.; Qu, K.; Tan, D.; Li, X.; Wang, L.; Cong, C.; Xiu, Z.; Xu, Y. Isolation and Characterization of a Bacteriophage and Its Potential to Disrupt Multi-Drug Resistant Pseudomonas aeruginosa Biofilms. Microb. Pathog. 2019, 128, 329–336. [Google Scholar] [CrossRef]
- Volozhantsev, N.V.; Shpirt, A.M.; Borzilov, A.I.; Komisarova, E.V.; Krasilnikova, V.M.; Shashkov, A.S.; Verevkin, V.V.; Knirel, Y.A. Characterization and therapeutic potential of bacteriophage-encoded polysaccharide depolymerases with β galactosidase activity against Klebsiella Pneumoniae K57 capsular type. Antibiotics 2020, 9, 732. [Google Scholar] [CrossRef]

| Bacterial Strains | Antibiotic Resistance Profile | Plaque Assay |
|---|---|---|
| P. aeruginosa ATCC 27853 | NR | + |
| P. aeruginosa strain M19 | MDR | + |
| P. aeruginosa PA14 | MDR | + |
| P. aeruginosa (Clinical isolate) | MDR | + |
| P. aeruginosa (Clinical isolate) | MDR | + |
| P. aeruginosa (Clinical isolate) | MDR | + |
| P. aeruginosa strain DW1 (Environmental isolate) | MDR | + |
| P. aeruginosa strain N155 (Environmental isolate) | XDR | - |
| P. aeruginosa strain YUSA1 (Environmental isolate) | XDR | - |
| P. aeruginosa (Environmental isolate) | XDR | - |
| P. aeruginosa (Environmental isolate) | MDR | + |
| Escherichia coli strain NRC129 | ESBLs | + |
| Escherichia coli strain NBRC 102203-68 | ESBLs | + |
| Escherichia coli strain E24 | ESBLs | + |
| Staphylococcus aureus | NR | - |
| Methicillin-resistant Staphylococcus aureus ATCC 43330 | MDR | - |
| Salmonella enterica subsp. enterica serovar Typhimurium strain FDAARGOS_321 | MDR | - |
| S. typhimurium strain CUB 32/10 | MDR | - |
| S. waycross strain SA20041608 | MDR | - |
| S. arizonae serovar 62:z4,z23 | MDR | - |
| S. enteritidis strain FORC_052 | MDR | - |
| Enterococcus sp. strain B43 | NR | - |
| Bacterium BEL C6 | NR | - |
| ORFs | Coverage | Length | Direction | Functions | Categories |
|---|---|---|---|---|---|
| ORF #4 | 5149–7266 | 2118 | Forward | Cell envelope integrity protein TolA | Head-associated proteins |
| ORF #6 | 7511–8503 | 993 | Forward | Putative capsid and scaffold protein | |
| ORF #7 | 8402–9361 | 960 | Reverse | Capsid and scaffold protein | |
| ORF #8 | 8522–9475 | 954 | Forward | Major capsid protein | |
| ORF #22 | 21,287–21,643 | 357 | Forward | Putative capsid decoration protein | |
| ORF #14 | 11,554–13,095 | 1542 | Forward | Tail protein | Tail-associated proteins |
| ORF #32 | 28,635–29,144 | 510 | Reverse | Tail-length tape measure protein | |
| ORF #13 | 10,898–11,545 | 648 | Forward | Tail fibers protein | |
| ORF #27 | 24,550–25,434 | 885 | Reverse | DNA polymerase I | DNA replication and regulation proteins |
| ORF #31 | 26,795–28,273 | 1479 | Reverse | DNA polymerase II | |
| ORF #37 | 30,360–30,869 | 510 | Reverse | DNA polymerase III | |
| ORF #38 | 30,853–32,094 | 1242 | Reverse | DNA primase | |
| ORF #45 | 37,796–38,803 | 1008 | Forward | Putative ligase-like domain-containing protein | |
| ORF #30 | 26,171–26,725 | 555 | Reverse | DNA-binding protein | |
| ORF #40 | 32,940–33,338 | 399 | Reverse | Putative glutamyl-tRNA amidotransferase | Protein biosynthesis |
| ORF #42 | 34,578–36,110 | 1533 | Reverse | Putative L-glutamine-D-fructose-6-phosphate amidotransferase | |
| ORF #24 | 22,642–23,403 | 762 | Reverse | Putative endonuclease | Packaging proteins |
| ORF #25 | 23,396–23,746 | 351 | Reverse | Putative endonuclease | |
| ORF #26 | 23,628–24,575 | 948 | Reverse | Endonuclease | |
| ORF #3 | 3700–5148 | 1449 | Forward | Terminase large subunit | |
| ORF #33 | 29,221–29,508 | 288 | Reverse | Putative holin | Cell lysis |
| ORF #10 | 9848–10,474 | 627 | Forward | Putative structural protein | Other structural proteins |
| ORF #20 | 17,204–20,374 | 3171 | Forward | Putative structural protein | |
| ORF #21 | 20,268–21,272 | 1005 | Forward | Putative structural protein | |
| ORF #18 | 15,137–15,520 | 384 | Forward | Putative structural protein | |
| ORF #19 | 15,525–17,048 | 1524 | Forward | Putative structural protein |
| tRNA# | tRNA Begin–End | tRNA Type | Anti-Codon | Introns Begin | Bounds End | Inf Score | Isotype CM | Score |
|---|---|---|---|---|---|---|---|---|
| 1 | 2461–2533 | Asn | GTT | 0 | 0 | 64.0 | Thr | 57.6 |
| 2 | 2541–2613 | Asp | GTC | 0 | 0 | 64.3 | Thr | 65.2 |
| 3 | 2713–2786 | Pro | TGG | 0 | 0 | 70.6 | Arg | 72.9 |
Disclaimer/Publisher’s Note: The statements, opinions and data contained in all publications are solely those of the individual author(s) and contributor(s) and not of MDPI and/or the editor(s). MDPI and/or the editor(s) disclaim responsibility for any injury to people or property resulting from any ideas, methods, instructions or products referred to in the content. |
© 2023 by the authors. Licensee MDPI, Basel, Switzerland. This article is an open access article distributed under the terms and conditions of the Creative Commons Attribution (CC BY) license (https://creativecommons.org/licenses/by/4.0/).
Share and Cite
Teklemariam, A.D.; Al-Hindi, R.R.; Alharbi, M.G.; Alotibi, I.; Azhari, S.A.; Qadri, I.; Alamri, T.; Esmael, A.; Harakeh, S. RETRACTED: Isolation and Characterization of a Novel Lytic Phage, vB_PseuP-SA22, and Its Efficacy against Carbapenem-Resistant Pseudomonas aeruginosa. Antibiotics 2023, 12, 497. https://doi.org/10.3390/antibiotics12030497
Teklemariam AD, Al-Hindi RR, Alharbi MG, Alotibi I, Azhari SA, Qadri I, Alamri T, Esmael A, Harakeh S. RETRACTED: Isolation and Characterization of a Novel Lytic Phage, vB_PseuP-SA22, and Its Efficacy against Carbapenem-Resistant Pseudomonas aeruginosa. Antibiotics. 2023; 12(3):497. https://doi.org/10.3390/antibiotics12030497
Chicago/Turabian StyleTeklemariam, Addisu D., Rashad R. Al-Hindi, Mona G. Alharbi, Ibrahim Alotibi, Sheren A. Azhari, Ishtiaq Qadri, Turki Alamri, Ahmed Esmael, and Steve Harakeh. 2023. "RETRACTED: Isolation and Characterization of a Novel Lytic Phage, vB_PseuP-SA22, and Its Efficacy against Carbapenem-Resistant Pseudomonas aeruginosa" Antibiotics 12, no. 3: 497. https://doi.org/10.3390/antibiotics12030497
APA StyleTeklemariam, A. D., Al-Hindi, R. R., Alharbi, M. G., Alotibi, I., Azhari, S. A., Qadri, I., Alamri, T., Esmael, A., & Harakeh, S. (2023). RETRACTED: Isolation and Characterization of a Novel Lytic Phage, vB_PseuP-SA22, and Its Efficacy against Carbapenem-Resistant Pseudomonas aeruginosa. Antibiotics, 12(3), 497. https://doi.org/10.3390/antibiotics12030497

